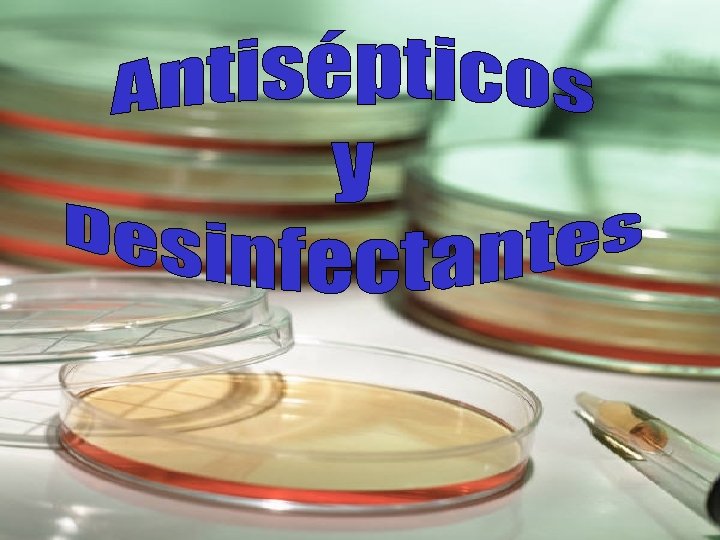

COMPLICACIONES DEL RECIEN NACIDO AUMENTAN LOS RIESGOS DE

- Slides: 67
COMPLICACIONES DEL RECIEN NACIDO AUMENTAN LOS RIESGOS DE INFECCION BAJO PESO AL NACER Menores 1500 gramos Ductus arterioso Procedimientos invasivos PREMATUREZ CESAREA Distrés respiratorio RUPTURA PREMATURA MEMBRANAS
AUSENCIA DE FLORA PROTECTORA Colonización con microorganismos del medio ambiente hospitalario después de nacer ◘ Enterobacterias ◘ Klebsiella sp. Variabilidad de la flora intestinal según TIPO DE ALIMENTACION
Bifidobacterias anaerobias (normal) Bacteroides Escherichia coli Ig A Macrófagos Linfocitos Lactoferrina Lisozima Escherichia coli Enterobacterias en general
AUMENTO DE LA ESTADIA DEL RECIEN NACIDO EN LA UCIN Prematurez Bajo peso al nacer Anormalidades congénitas Anoxia perinatal CVC Procedim. invasivos ARM SV
ALTERACIONES EN LAS BARRERAS NATURALES DE DEFENSA DEFECTOS CONGENITOS PIEL AP. RESP. q RN – 32 semanas • Inmadura y frágil • Permeable a los antígenos externos q RN + 2 semanas de vida • Madurez • Desarrollo del estrato córneo • Riesgo aumentado Enf. Pulmonar Crónica (displasia broncopulmonar) • Disminución de la función mucociliar
INMADUREZ DEL SISTEMA INMUNE Al nacer cuentan con un pequeño nº de anticuerpos transferidos por su madre Hasta el 2º trimestre de vida
Bazo: no puede remover los antígenos exógenos circulantes en sangre Mayor alteración inmune cuando se presenta - hipoxia - acidosis - hiperbilirrubinemia - enfermedades metabólicas
INFECCIONES GERMENES SEPSIS INMEDIATAS - El 25 % RN BSI contrae MEN Asociadas con: • Infecciones maternas (ITU) • Prematurez, BPN, RPM § Streptococcus grupo B § Escherichia coli § Listeria sp. § Haemophylus influenzae § Enterococcus sp. SEPSIS TARDIAS • Más 7 días del nacimiento • Asociadas frecuentemente con MEN o ITU § Streptococcus grupo B § Escherichia coli § Listeria sp.
INFECCIONES GERMENES SEPSIS HOSPITALARIAS -Antes de los 30 días de internación en la UCIN - Factores de riesgo: • BPN, CVC, Hiperalimentación (Lípidos), cirugía § Staphylococcus coagulasa negativo (SCN) (Biofilm) § Staphylococcus aureus § Enterococcus sp. § Bac. Gram negativos (Pseudomonas sp. ) SEPSIS HOSPITALARIAS - Después de los 30 días de internación en la UCIN § SCN § Cándida sp. NEUMONIAS § Bac. Gram negativos (Pseudomonas sp. ) § Staphylococcus aureus § SCN § Enterococcus sp.
INFECCIONES GERMENES DEL TRACTO URINARIO • 0, 5 % RN término • 3 % RN prematuro • SV : aumenta los riesgos § Escherichia coli § SCN § Bac. Gram negativos (Pseudomonas sp. ) § Enterococcus sp. § Cándida sp. § Staphylococcus aureus (Más frecuente) ISQ • 16 % OTRAS PIEL Y PARTES BLANDAS • Onfalitis, celulitis, conjuntivitis hospitalaria, • S. Piel escaldada • Shock estafilocóccico § Staphylococcus aureus (el 50 % de los RN se coloniza a los pocos días) § Enterococcus sp.
INFECCIONES GERMENES OTRAS • Osteomielitis • Artritis § Staphylococcus aureus • Mucosa oral • Piel § Cándida albicans § Cándida parapsilosis § Cándida tropicalis • Endoftalmitis § Pseudomonas aeruginosa
INFECCIONES GERMENES GASTROENTERITIS § Rotavirus - Puede ser endémico -Transmisión fecal – oral - Brotes: 50 % pacientes - Infecc. asintomáticas - Diarrea: inmadurez intestinal § Salmonella sp. – Invasiva : sepsis § Escherichia coli enteropatógena • p. H gástrico aumentado • Disminución del vaciado gástrico NEC • Inmadurez tracto intestinal § No se han hallado microorganismos que sean causa directa
Digame por favor!!! Tengo un brote en la UCIN? Antes de investigar un BROTE o EPIDEMIA hay que definir si EXISTE REALMENTE !!!! DEFINIR “CASO”
DEFINIR “CASO” “CASOS” son los pacientes afectados por un mismo microorganismo (generalmente en un mismo medio de cultivo) y que presentan signos y síntomas similares, en un mismo lugar geográfico del hospital y en un lapso de tiempo determinado
¿ COLONIZADO O INFECTADO ? - ¿ Cuál es la diferencia ? Las personas que portan bacterias sin evidencia de infección (fiebre, aumento de glóbulos blancos) están colonizadas Cuando la infección tiene lugar, usualmente es a partir de bacterias que estaban colonizando al paciente Las bacterias que colonizan a un paciente, pueden ser transmitidas de un paciente a otro a través de las manos del personal Las bacterias pueden ser transmitidas aún cuando el paciente no esté infectado
q q q S. aureus Klebsiella sp. Proteus mirabilis E. coli Salmonella sp. Reservorio común -1 paciente Pasaje a otros pacientes TRANSMISION Manos del personal Otros reservorios de microorganismos q q q Solución salina (ojos) Jabón líquido AMPOLLAS ABIERTAS Antisépticos Soluc. endovenosas q Hiperalimentación q ARM = TET q TELA ADHESIVA
Colonización de catéteres por SCN Tipo de Catéteres UMBILICALES PERIFERICOS CENTRALES ARTERIALES FEMORALES q No cultivar en forma rutinaria ðCatéteres ðMedio ambiente ðPersonal q SOLO EN BROTES
LAVARSE LAS MANOS ? PARA QUE ? PORQUE ? Para prevenir la transmisión de infecciones asociadas al cuidado de la salud
MICROORGANISMOS DE LA PIEL DE LAS MANOS FLORA MICROORGANISMOS UBICACION TRANSITORIA § Escherichia coli § Pseudomonas sp. § Serratia sp. § S. aureus § Enterococcus sp. Toda la superficie de la piel de las manos. § Staphylococcus coagulasa negativo § “Difteroides” Glándulas sudoríparas Debajo de las uñas RESIDENTE, HABITUAL O NORMAL Se adquieren durante las actividades de cuidado de pacientes y contacto con superficies
Los microorganismos pueden sobrevivir horas o días en. . Grietas lesiones, cortes, piel irritada, etc.
TIPOS DE LAVADO DE MANOS LAVADO SOCIAL : Con agua y jabón líquido común LAVADO ANTISEPTICO: Con agua y jabón u otros detergentes líquidos antisépticos FROTADO CON SOLUCIONES DE BASE ALCOHOLICA: Con preparaciones que contengan alcohol LAVADO DE MANOS QUIRURGICO: Con agua y jabón u otros detergentes líquidos antisépticos o frotado con soluciones de base alcohólica (previo lavado social) Guideline for Hand Hygiene in Health – care Settings. MMWR 2002; vol. 51, Nº RR - 16
PARA LA HIGIENE DE LAS MANOS
¿ CUANDO DEBEN LAVARSE LAS MANOS ? Cuando las manos están visiblemente manchadas, contaminadas o sucias lavar las manos con agua y soluciones jabonosas comunes o antimicrobianas Si las manos NO están visiblemente sucias o manchadas, practicar frotado de ambas manos con soluciones de base alcohólica Guideline for Hand Hygiene in Health – care Settings. MMWR 2002; vol. 51, Nº RR - 16
TECNICA RECOMENDADA PARA EL LAVADO DE MANOS Con agua y jabón - Mojar las manos, aplicar la solución jabonosa, frotar ambas manos durante al menos 15 segundos - Enjuagar y secar con toallas descartables - Usar la toalla para cerrar la canilla Frotado con soluciones de base alcohólica - Aplicar la solución sobre la palma de una mano y frotarse las dos manos, una contra otra, abarcando todas las superficies Guideline for Hand Hygiene in Health – care Settings. MMWR 2002; vol. 51, Nº RR - 16
1. Aplicar 2 ml en la palma de la mano derecha 2. Frotar las uñas de la mano izquierda y extender el resto de la solución de base alcohólica por todos los dedos de la mano, pliegues interdigitales llegando hasta la muñeca inclusive de la mano izquierda. 3. Aplicar 2 ml en la palma de la mano izquierda , frotar las uñas de la mano derecha y extender el resto de la solución de base alcohólica por todos los dedos de la mano, pliegues interdigitales llegando hasta las muñeca inclusive de la mano derecha. 4. Friccionar hasta que se seque totalmente , especialmente si van a utilizarse guantes
EFICACIA DE LOS DIFERENTES PRODUCTOS EN LA DESTRUCCION BACTERIANA Buena Mejor Optima Jabón común Jabón antimicrobiano Frotado con soluciones de base alcohólica
q La adherencia al lavado de manos disminuye cuando no hay una relación adecuada enfermera – paciente en UCIN
UÑAS NATURALES Y ARTIFICIALES El largo de las uñas naturales debe mantenerse en menos de 1 mm No deben utilizarse uñas artificiales cuando se brindan cuidados a pacientes de alto riesgo (Ej. UCIN) Guideline for hand hygiene in Health – care settings. MMWR 2002; Vol. 51, no. RR - 16 www. cdc. gov/handhygiene - 2002 SAFER – HEALTHIER – PEOPLE TM
• Piletas de uso exclusivo, profundas para minimizar salpicaduras en el medio ambiente • Usar uñas cortas y sin esmalte Arrowsmith VA, Maunder JA, Sargent RJ, Taylor R. Eliminación del esmalte de uñas y extracción de anillos para prevenir la infección quirúrgica (Revisión Cochrane traducida) Biblioteca Cochrane Plus. Nº 1. 2005. (ISNN 1745 – 9990) Oxford, Update software Ltd. / www. update-software. com. uk
• El uso de anillos fue encontrado como el mayor factor de riesgo de contaminación de las manos • El riesgo es mayor cuando hay presencia de más de un anillo
• La presencia de BGN, S. aureus y Cándida sp. fue más alta en el grupo que usaba anillos • Mayor cantidad de ufc asociada con el nº de anillos • Las enfermeras que usan anillos tienen menor adherencia a las prácticas relacionadas con las medidas de control de infecciones
USO DE GUANTES Doebbeling et al. demostraron que no es prudente lavarse las manos con los guantes puestos. La textura de la piel es diferente a la del látex, que se daña con los antisépticos REMOVER SIEMPRE DESPUES DE USAR öLas bacterias pueden penetrar a través de los guantes debido a fallas de fabricación (rango 3 – 18 %), rupturas o punciones no percibidas öLos guantes se contaminan por contacto con la Unidad del paciente y pueden contaminar luego otras superficies: mesadas, teléfonos, tela adhesiva, etc.
Los estudios realizados en el mundo han demostrado que el porcentaje de lavado de manos no supera el 50 % Mejor para mí. . . !!! Si bien la mayoría de los trabajadores de la salud reconoce la importancia del lavado de manos. . . La mayoría NO LO PRACTICA !!!
Riesgos para la no aceptación del LAVADO DE MANOS – ESTUDIOS DE OBSERVACION î Ser medico (se lavan menos que las enfermeras/os) î Sexo masculino î Trabajar en UCI î Trabajar durante la semana (vs. fines de semana) î Usar camisolines y guantes î Piletas automáticas î Actividades de alto riesgo de infección cruzada
FACTORES AUTODENUNCIADOS PARA EXPLICAR LA POBRE ADHERENCIA DEL PERSONAL AL LAVADO DE MANOS – ENCUESTAS îUso de productos que producen irritación y sequedad de la piel îNúmero escaso de piletas îPiletas mal ubicadas îDisrupción en la presencia de jabón y/o toallas de papel îTiempo insuficiente îDisminución o aumentos exagerados de personal î“El paciente tiene otras prioridades” î“El lavado de manos interfiere en la relación paciente – personal de salud” î“Existe un riesgo muy bajo de adquirir y transmitir infecciones a partir de los pacientes”
îUso de guantes (creencia de que no es necesario lavarse las manos) îInexistencia de programas o recomendaciones escritas îNo se piensa ni se internaliza su importancia îInexistencia de un rol modelo por parte de superiores (Jefes y supervisores que no lavan sus manos) Hand hygiene and patient care: pursuing the Semmelweis legacy. Didier Pittet, John Boyce. THE LANCET. Infectious Diseases. April 2001
El medio ambiente inanimado puede facilitar la transmisión X Representa los cultivos positivos de Enterococo resistente a vancomicina (ERV) Las superficies contaminadas incrementan los riesgos de transmisión cruzada
Muchos microorganismos pueden permanecer en el medio ambiente hospitalario durante muchos días, especialmente en la unidad del paciente ® No basta lavar las manos ®Hay que evitar su recontaminación q Limpiar y desinfectar la unidad del paciente a diario
NO OLVIDAR!!!! Limpiar y desinfectar diariamente los elementos que integran la unidad del paciente. Los microorganismos del paciente se depositan en ellos CLORO D E T E R G E N T E
Desinfectar diariamente las puertas de la incubadora Gram negativos
Limpieza y desinfección exterior METODO 1 1) Limpieza con detergente biodegradable o detergente enzimático. Pulverizar sobre las superficies 2) Enjuagar con agua corriente fría de fuente confiable 3) Desinfectar con hipoclorito de sodio al 1%
METODO 2 Limpieza y desinfección simultáneas 1) Pulverizar las superficies con el producto elegido en forma directa o con un trapo limpio. Productos: Productos Peroxomonosulfato de potasio estabilizado (LT 8) 2) Esperar que actúe 10’ 3) Secar con compresa limpia
Limpieza interior de una incubadora en uso METODO 1 1) Limpieza con detergente biodegradable o detergente enzimático 2) Enjuagar con agua corriente fría de fuente confiable El paciente no debe estar dentro de la incubadora (aprovechar cuando se baña, lo amamantan, lo cambian, etc. ) Usar siempre sábanas limpias, incluso para preparar los “nidos” METODO 2 Limpieza y desinfección simultáneas
No se requiere desinfección diaria de la parte interna de la incubadora (Solo limpieza) (mismo paciente) Limpieza y desinfección de la incubadora al alta o cuando se encuentra fuera de uso Cambio de Incubadora: cada 5 a 7 días
Lavar los trapos usados Sumergirlos en hipoclorito de sodio al 1 % durante 5 minutos) Dejar siempre extendidos para que sequen Alternativa: usar apósitos no estériles específicamente preparados para tal fin Descartar luego de usar CLORO La incubadora debe desarmarse totalmente para poder practicar adecuadamente el proceso de limpieza y desinfección al alta del paciente
Orden de limpieza y/o desinfección de la incubadora Retirar el colchón, limpiarlo y/o desinfectarlo L/D la parte interna de la incubadora L/D las puertas de acceso (Especialmente zona de burletes de ajuste) L/D exteriormente por los cuatro costados y la parte superior L/D patas y bandejas y/o cajoncitos que algunas incubadoras tienen para el apoyo de elementos del paciente Limpiar ruedas de la incubadora.
Tela adhesiva USO PRUDENTE INDIVIDUAL ROLLOS PEQUEÑOS Hongos: Rhizopus, Aspergillus Cándida, Fusarium Bacterias: Pseudomonas aeruginosa (3 semanas), Clostridium perfringens, Tetanii y Bacillus cereus
AISLAMIENTO DE CONTACTO Gérmenes multirresistentes (MMR) Huésped Forma de transmisión ® Elementos de protección personal ® Elementos de seguridad general ®Prácticas específicas
USO RACIONAL DE ANTIBIOTICOS • La exposición a los antibióticos pueden promover la emergencia de resistencia bacteriana, incluso cuando son utilizados de manera adecuada, tanto profiláctica como terapéuticamente. EL ANTIBIOTICO NO PUEDE SER UTILIZADO COMO “ANSIOLITICO” DEL MEDICO
Antisépticos: se aplica sobre piel y tejidos. Desinfectantes: se aplica sobre superficies y elementos biomédicos
Gluconato de Clorhexidina al 4 %: ANTISEPTICO Eficacia Acción Mecanismo Acción Toxicidad reducida baja de acción residual Gram (+) Gram (-) Bacilo de koch S. Aureus Hongos Virus no lipídicos Lipídicos (Herpes (Rotavirus, ADV, simple, enterovirus) HIV, CMV, VSR) Conservación Adhesión y Sobre la Daños Al abrigo ruptura de las piel: 3 a severos en la de la luz, membranas 6 hs. córnea y a citoplasmáticonjuntivitis. temperatu cas Otoxicidad ra bacterianas, Dermatitis ambiente precipitando y en su de contacto el contenido envase prolongado celular original No debe usarse para desinfección de elementos o superficies. No es esporicida. Se inactiva en presencia de materiales como corcho, algodón o goma.
Iodopovidona: ANTISÉPTICO Eficacia Gram (+) Gram (-) Algunas bacterias formadoras de esporas (Clostridium y Bacillus spp. ) Virus Micobacterias Acción Mecanisreducida mo de acción Hongos Acción residual Actúa por Pobre ruptura de sobre la las piel: 30 a estructura 60 s celulares, segundos afectando la síntesis de proteínas y ácidos nucleicos. Toxicidad Conservación Puede absorberse a través de cualquier superficie corporal. Algunas reacciones alérgicas Al abrigo de la luz, a temperatura ambiente y en su envase original El rol antiséptico se halla íntimamente relacionada con el tiempo de contacto con la piel (1 a 2’). Esperar que se seque.
Alcohol: ANTISÉPTICO Y DESINFECTANTE Eficacia Acción baja Mecanismo de acción Acción residual Toxici- Conserv dad ación Gram (+) Virus no Por No posee. No Almacena lipídicos, desnaturalizació presenta. dos en S. Aureus La bacterias n de las zonas (SAMR) recolonizaci formadoras proteínas. frescas ón de las ERV de esporas bien La manos es Gram (-) y ventiladas concentración lenta. B. de Koch protozoos. ideal es del 70%, Efectividad debido a Hongos que el debido a que es para el alcohol es Virus lipídicos necesaria la lavado de inflamable (HS, Hep. B y C, presencia de manos INF, VSR, HIV) agua. 99. 97 % No es adecuado usar cuando las manos están visiblemente sucias. Desinfectante: sólo para termómetros y elementos de vidrio. Inmersión de 20 minutos.
PEROXIDO DE HIDROGENO (Agua oxigenada): ANTISÉPTICO Eficacia Mecanismo de acción Acción Conservación residual Leve efecto germicida. Actúa sobre los No posee. Al abrigo de la lípidos de las luz, a Se degrada fácilmente a menbranas, temperatura oxígeno molecular y ADN y enzimas ambiente y en su agua. esenciales. envase original Bactericida, virucida, funguicida, tuberculicida No puede usarse como desinfectante. Corroe material como cobre, aluminio y zinc.
ALMACENAMIENTO Y USO DE ANTISEPTICOS üPoner en uso con válvula de seguridad dispensadora. üColocar fecha en la puesta en uso üDescartar sobrantes cada 48 hs. üLimpieza de frascos con detergente enzimat. , enjuagar con agua corriente. Esterilizar en O. E. üNUNCA DEBEN RELLENARSE SI NO ESTAN ESTÉRILES. JABON COMUN NO ANTIMICROBIANO PARA EL LAVADO DE MANOS Actividad limpiadora, remueve lípidos y suciedad adherida, tierra y varias sustancias orgánicas presentes en las manos. La actividad antimicrobiana es mínima. Remueve la flora transitoria de las manos ES NEGLIGENCIA EL USO DE JABONES EN BARRA
HIPOCLORITO DE SODIO (Agua Lavandina): DESINFECTANTE Clorado inestable. Se degrada la acción de la luz y el calor Actúa siempre que se haya realizado una buena limpieza previa de las superficies a tratar Debe prepararse con agua fría. (thialometano) Preparar la solución cada 24 hs y descartarlo si no es utilizada. Corrosivo para material metálico Se inactiva frente a materia orgánica, no debe mezclarse con detergentes u otras sustancias limpiadoras
PEROXOMONOSULFATO DE POTASIO ESTABILIZADO. (LT 8 – ADOX) Limpieza y desinfección simultánea en un solo paso. La presencia de materia orgánica no interfiere en la acción del producto 1º componente: polvo activo 2º componente: solución activadora Una vez reconstituido el producto, dura 24 hs Rociar sobre las superficies o un trapo húmedo sobre equipos. Dejar actuar 10’ y luego secar con una compresa limpia. DESINFECTANTE ALTO NIVEL: 45’ sumergido